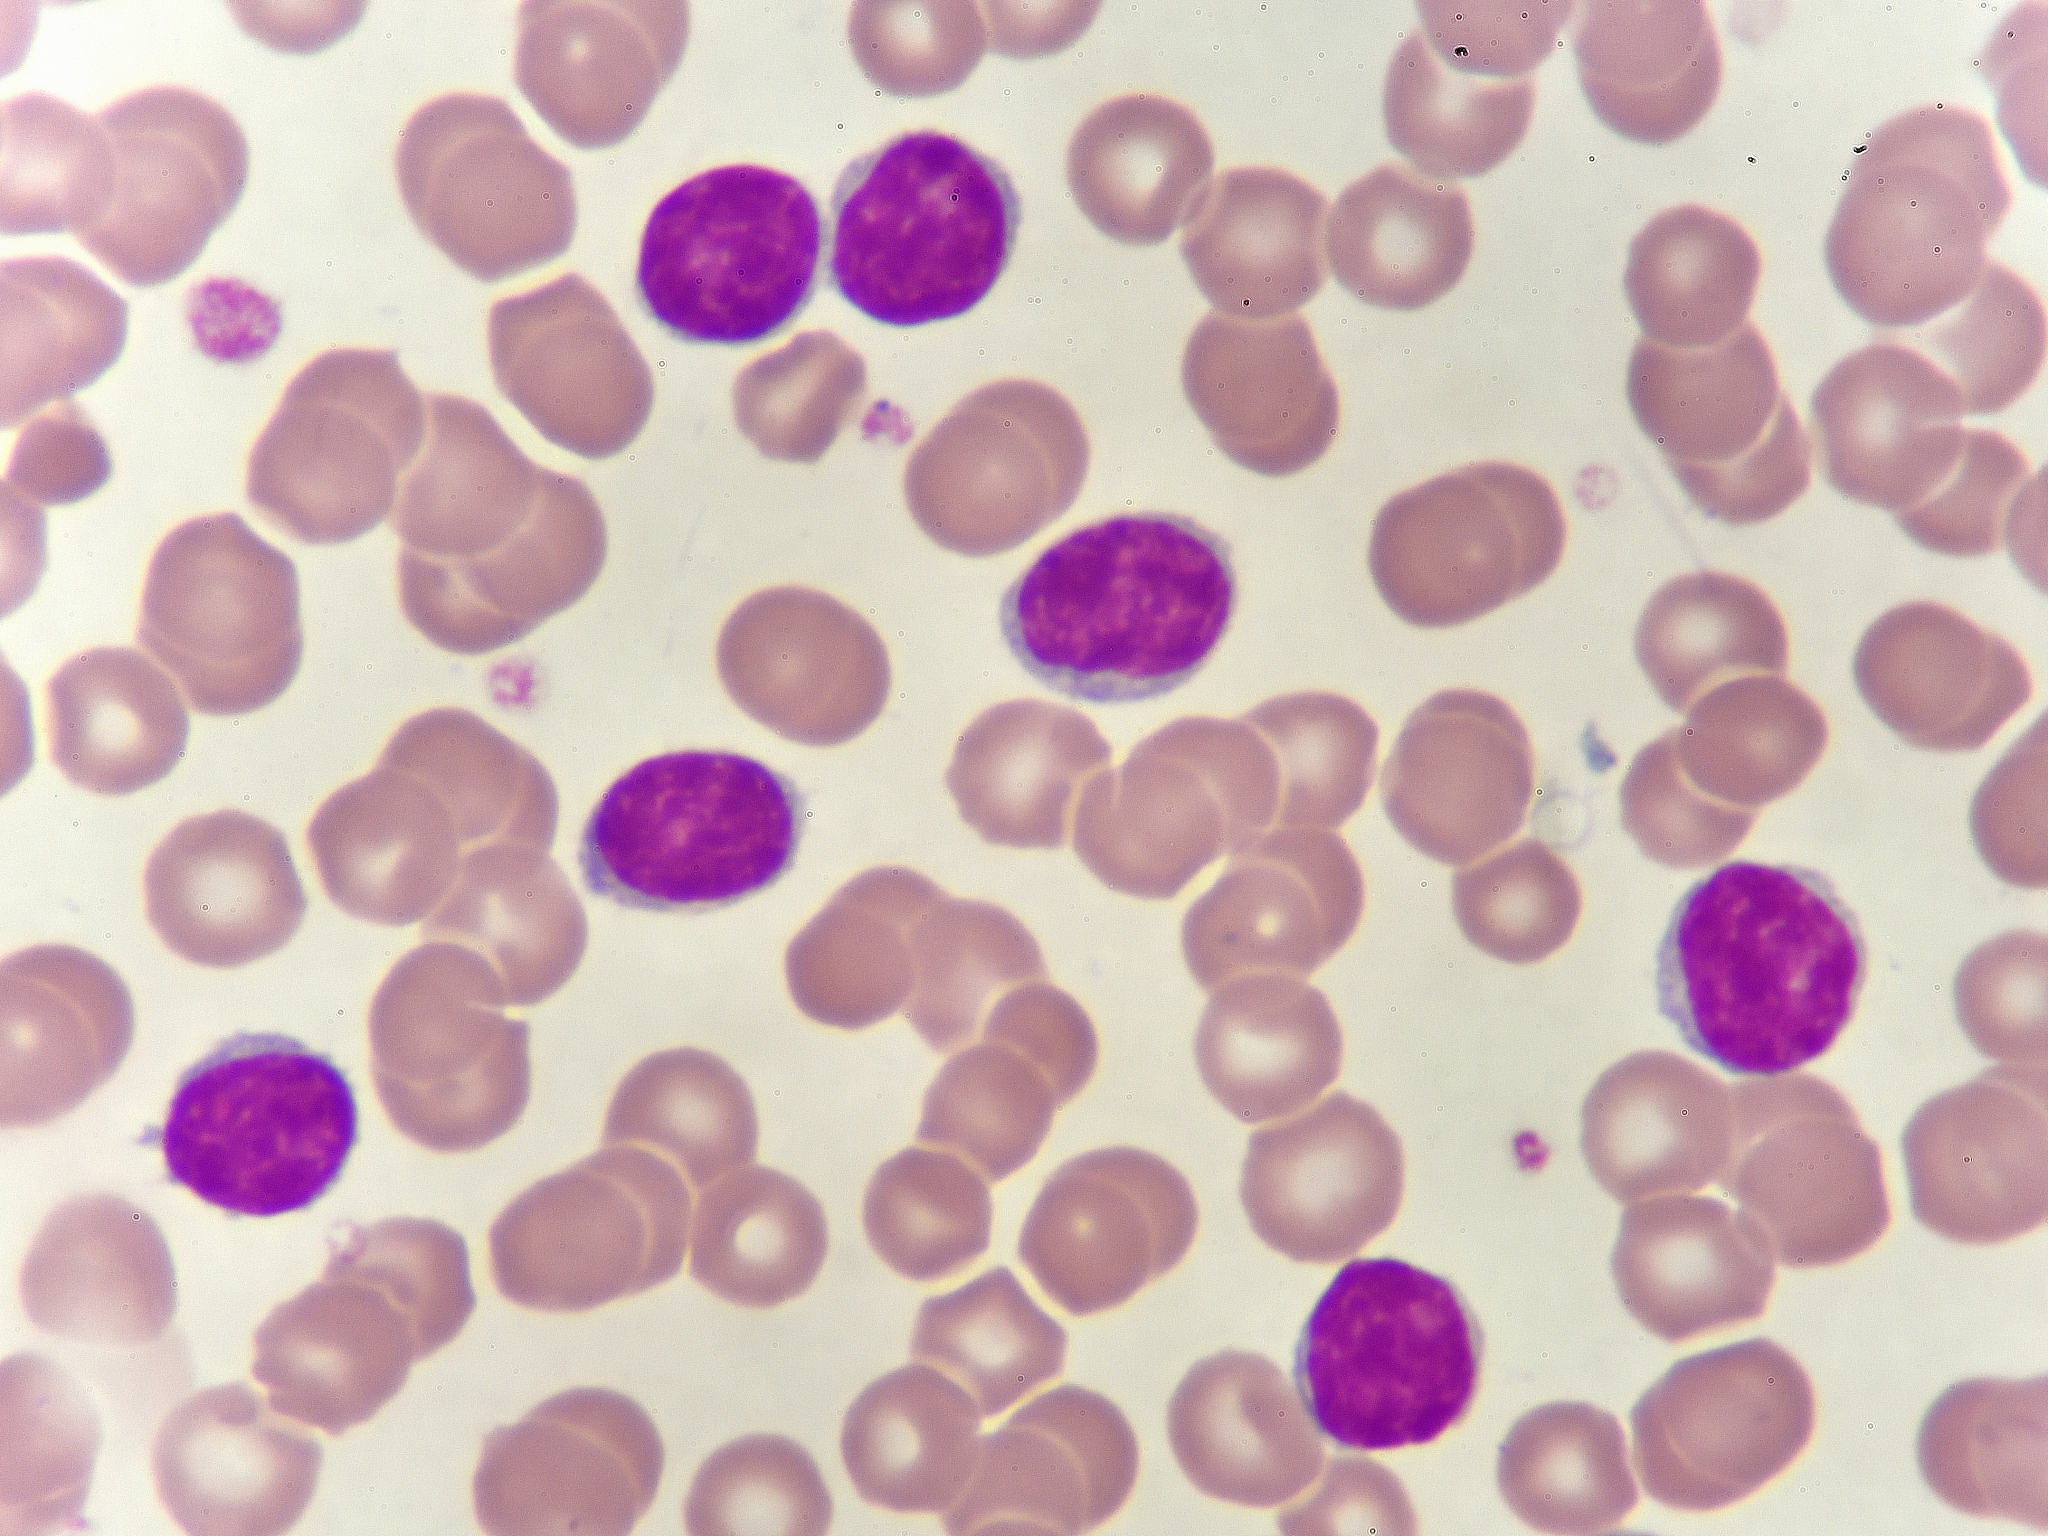
灵菌红素抑制金光色葡萄球菌诱导巨噬细胞炎症

灵菌红素抑制金光色葡萄球菌诱导巨噬细胞炎症
灵菌红素可以抑制金光色葡萄球菌对巨噬细胞发生炎症作用的促进作用。这是因为灵菌红素具有抗炎作用,可以抑制炎症反应的发生。此外,灵菌红素还可以调节免疫系统的功能,增强机体的免疫力,从而对抗细菌感染。因此,灵菌红素有望成为治疗细菌感染和炎症的新型药物。

原文地址: https://www.cveoy.top/t/topic/lHhN 著作权归作者所有。请勿转载和采集!
安全问答是一个知识全球问答,包含丰富的问答知识
灵菌红素可以抑制金光色葡萄球菌对巨噬细胞发生炎症作用的促进作用。这是因为灵菌红素具有抗炎作用,可以抑制炎症反应的发生。此外,灵菌红素还可以调节免疫系统的功能,增强机体的免疫力,从而对抗细菌感染。因此,灵菌红素有望成为治疗细菌感染和炎症的新型药物。
原文地址: https://www.cveoy.top/t/topic/lHhN 著作权归作者所有。请勿转载和采集!